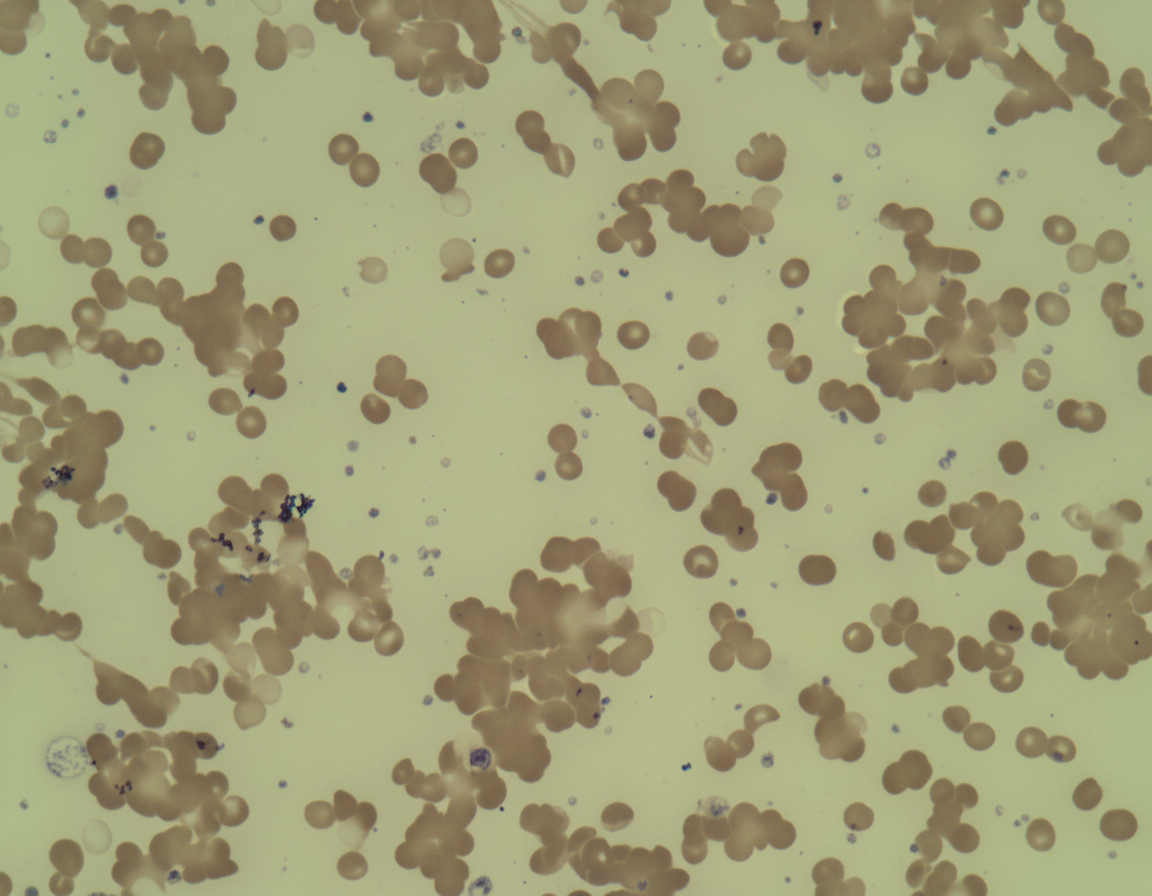
Image for question 599

What is the other name for Cooley's anemia?
Which tumor is associated with polycythemia?
A 16-year-old female presents with generalized weakness and palpitations. Her Hb is 7 g/dL and peripheral smear shows microcytic hypochromic anemia. Reticulocyte count is 0.8%. Serum bilirubin is 1 mg%. What is the most likely diagnosis?
All of the following conditions cause thrombocytopenia except?
Secondary hemolytic anemia is seen in all except:
Which of the following statements about Schilling's test is false?
What is the most common cause of death in patients with Hemophilia B?
Hepatitis-associated aplastic anemia is caused by which type of hepatitis virus?
A 25-year-old female presented in December with chronic fatigue and cyanosis with bluish lips and arthralgia. Peripheral blood film is shown below. What is the likely cause?
Upshaw-Schulman syndrome is classified as:
Explanation: **Explanation:** **Beta thalassemia major** is also known as **Cooley’s anemia**, named after Dr. Thomas Benton Cooley who first described the condition in 1925. It is a severe microcytic hypochromic anemia caused by a homozygous mutation (or compound heterozygous state) in the beta-globin gene, leading to a near-total absence of beta-chain synthesis [1]. This results in an excess of alpha-chains, which precipitate and cause ineffective erythropoiesis and hemolysis. **Analysis of Options:** * **Beta thalassemia minor (Option B):** Also known as "Thalassemia trait," this is a heterozygous state where patients are usually asymptomatic or have mild anemia. It is not referred to as Cooley's anemia. * **Aplastic anemia (Option C):** This is a condition of bone marrow failure leading to pancytopenia. It is unrelated to hemoglobin synthesis defects. * **Pernicious anemia (Option D):** This is a megaloblastic anemia caused by Vitamin B12 deficiency due to a lack of intrinsic factor (autoimmune etiology). **High-Yield Clinical Pearls for NEET-PG:** * **Radiology:** Look for the **"Hair-on-end" appearance** on skull X-rays and "Crew-cut" appearance due to compensatory extramedullary hematopoiesis. * **Facies:** "Chipmunk facies" (prominent maxilla and malar bones) occurs due to expansion of the marrow cavity. * **Diagnosis:** Gold standard is **Hb Electrophoresis**, which shows significantly increased **HbF** (up to 90%) and absent/low HbA [2]. * **Complication:** Frequent blood transfusions lead to **secondary hemochromatosis** (iron overload), necessitating chelation therapy (e.g., Deferasirox).
Explanation: ### Explanation The correct answer is **Cerebellar hemangioblastoma**. **1. Why Cerebellar Hemangioblastoma is Correct:** Polycythemia in the context of malignancy is usually a **paraneoplastic syndrome** caused by the ectopic production of **Erythropoietin (EPO)**. Cerebellar hemangioblastoma is a classic "EPO-secreting tumor" [1]. These tumors are highly vascular and are frequently associated with **Von Hippel-Lindau (VHL) syndrome**. The excess EPO stimulates the bone marrow to increase red blood cell production, leading to secondary polycythemia (erythrocytosis) [1]. **2. Why Other Options are Incorrect:** * **Sarcoma:** While some rare sarcomas (like uterine fibroids/leiomyomas) have been sporadically linked to erythrocytosis, "Sarcoma" as a general category is not a classic or high-yield association for polycythemia. * **Pituitary Adenoma:** These tumors typically present with hormonal excesses (like GH in acromegaly or ACTH in Cushing’s) or mass effect symptoms (visual field defects). They do not typically secrete EPO. **3. High-Yield Clinical Pearls for NEET-PG:** To master questions on ectopic EPO production, remember the mnemonic **"Potentially Really High Hematocrit"**: * **P:** **P**heochromocytoma * **R:** **R**enal Cell Carcinoma (The most common cause) [1] * **H:** **H**epatocellular Carcinoma (HCC) [1] * **H:** **H**emangioblastoma (Cerebellar) [1] * **Uterine Leiomyoma:** Occasionally associated (Myomatous Erythrocytosis Syndrome) [1]. **Key Distinction:** * **Primary Polycythemia (Polycythemia Vera):** Low EPO levels (due to JAK2 mutation). * **Secondary Polycythemia (Paraneoplastic):** High EPO levels (due to ectopic secretion by the tumors listed above) [1].
Explanation: ### Explanation The correct diagnosis is **Iron Deficiency Anemia (IDA)**. This conclusion is based on the integration of the clinical presentation and laboratory findings: 1. **Microcytic Hypochromic Anemia:** The peripheral smear shows small, pale red blood cells [2]. This is the hallmark of impaired hemoglobin synthesis, most commonly caused by iron deficiency [1]. 2. **Low Reticulocyte Count (0.8%):** A reticulocyte count <2% indicates an **underproduction anemia** (bone marrow failure or nutrient deficiency) rather than a regenerative response to blood loss or hemolysis. 3. **Normal Bilirubin:** A serum bilirubin of 1 mg% (normal range) rules out significant active hemolysis. #### Why the other options are incorrect: * **Hemolytic Anemia:** While it can cause weakness, it typically presents with a **high reticulocyte count** (compensatory erythropoiesis) and **indirect hyperbilirubinemia** (jaundice) due to RBC breakdown. * **Aplastic Anemia:** This presents as **pancytopenia** (low RBCs, WBCs, and platelets). While the reticulocyte count is low, the smear is usually **normocytic normochromic**, not microcytic. * **Folic Acid Deficiency:** This is a megaloblastic anemia characterized by **macrocytic** (large) RBCs and hypersegmented neutrophils on the peripheral smear. #### NEET-PG High-Yield Pearls: * **Most common cause of microcytic hypochromic anemia:** Iron Deficiency Anemia (Global and India) [1]. * **Mentzer Index:** (MCV/RBC count) >13 suggests IDA; <13 suggests Thalassemia trait. * **Earliest sign of response to Iron therapy:** Increase in reticulocyte count (peaks at 7–10 days). * **Serum Ferritin:** The most sensitive and specific biochemical test to diagnose iron deficiency.
Explanation: **Explanation:** The correct answer is **Iron deficiency anemia (IDA)** because it is typically associated with **thrombocytosis (increased platelet count)** rather than thrombocytopenia. **1. Why Iron Deficiency Anemia is the Correct Answer:** In IDA, reactive thrombocytosis is a common finding. The underlying mechanism is thought to be a compensatory surge in erythropoietin (EPO) levels due to anemia; because EPO and thrombopoietin (TPO) share structural homology, high levels of EPO can stimulate megakaryocytes to produce more platelets. Additionally, iron is a known inhibitor of megakaryopoiesis; thus, its absence removes this "brake," leading to increased platelet production [2]. **2. Analysis of Other Options:** * **Giant Hemangioma (Option A):** Associated with **Kasabach-Merritt Syndrome**, where platelets are trapped and consumed within the vascular tumor (consumptive thrombocytopenia). * **Infectious Mononucleosis (Option B):** Caused by EBV, it can cause thrombocytopenia via immune-mediated destruction (anti-platelet antibodies) or splenic sequestration due to splenomegaly. * **HIV Infection (Option C):** Thrombocytopenia is a common hematological manifestation of HIV, occurring via direct infection of megakaryocytes, immune-mediated destruction (ITP-like), or bone marrow suppression [1]. **Clinical Pearls for NEET-PG:** * **Reactive Thrombocytosis:** Always consider IDA, acute hemorrhage, or post-splenectomy when you see a high platelet count [4]. * **Kasabach-Merritt Syndrome:** Classic triad of giant hemangioma, thrombocytopenia, and consumptive coagulopathy. * **Pancytopenia:** While IDA causes thrombocytosis, **Vitamin B12/Folate deficiency** typically causes pancytopenia (including thrombocytopenia). **Note:** Hemolytic-uremic syndrome is another condition that involves both thrombocytopenia and anemia [3].
Explanation: The question asks to identify the condition **not** typically associated with secondary hemolytic anemia. **1. Why CML (Chronic Myeloid Leukemia) is the correct answer:** CML is a myeloproliferative neoplasm characterized by the overproduction of mature granulocytes [1]. While it can cause anemia due to bone marrow overcrowding (myelophthisis) or hypersplenism, it is **not** classically associated with immune-mediated or mechanical hemolysis. In contrast, lymphoproliferative disorders like CLL are notorious for secondary autoimmune phenomena. **2. Analysis of Incorrect Options:** * **CLL (Chronic Lymphocytic Leukemia):** This is a classic cause of **Warm Autoimmune Hemolytic Anemia (WAIHA)**. In up to 10% of cases, the neoplastic B-cells produce autoantibodies against RBC antigens, leading to secondary hemolysis. * **CRRT and ECMO:** Both are forms of extracorporeal circuits. Hemolysis in these settings is **mechanical (Microangiopathic Hemolytic Anemia - MAHA)**. High shear stress, turbulent blood flow, and contact with artificial surfaces (cannulas, pumps, and filters) lead to physical fragmentation of erythrocytes (schistocytes) [2]. **Clinical Pearls for NEET-PG:** * **Evans Syndrome:** The combination of AIHA and Immune Thrombocytopenic Purpura (ITP), often seen secondary to CLL or SLE. * **MAHA Markers:** Look for increased LDH, decreased haptoglobin, and the presence of **schistocytes** (helmet cells) on peripheral smear [2]. * **CML Key Finding:** The hallmark is the **Philadelphia chromosome t(9;22)** and a low Leukocyte Alkaline Phosphatase (LAP) score, which helps differentiate it from a leukemoid reaction [1].
Explanation: The Schilling test is a classic diagnostic tool used to determine the cause of Vitamin B12 (cobalamin) deficiency. The liver stores enough vitamin B12 for 3 years, meaning deficiency takes years to become manifest even if malabsorption occurs [1]. **Explanation of the Correct Answer:** The question asks for the **false** statement. Option D is false because **58Co-labeled cobalamin is administered orally**, not intramuscularly. In the Schilling test, a small dose of radiolabeled B12 is given orally, followed by a large "flushing dose" (1000 µg) of non-labeled B12 given **intramuscularly** to saturate transcobalamin receptors and ensure that any absorbed radiolabeled B12 is excreted in the urine. **Analysis of Other Options:** * **Option A (Abnormal in Pernicious Anemia):** This is true. In Pernicious Anemia (PA), the lack of Intrinsic Factor (IF) prevents B12 absorption [1]. The test becomes "normal" in Stage II when exogenous IF is co-administered with B12. * **Option B (Dependent on normal renal function):** This is true. Since the test measures the radioactivity of B12 excreted in a **24-hour urine collection**, renal failure or incomplete urine collection will yield false-positive results (low excretion). * **Option C (Abnormal in ileal disease):** This is true. Vitamin B12 is absorbed in the terminal ileum [1]. If the ileum is diseased (e.g., Crohn’s disease), B12 absorption remains low even if Intrinsic Factor is added (Stage II remains abnormal). **NEET-PG High-Yield Pearls:** * **Stage I:** Radiolabeled B12 alone (Low excretion = Malabsorption). * **Stage II:** B12 + Intrinsic Factor (Corrects in Pernicious Anemia). * **Stage III:** B12 + Antibiotics (Corrects in Blind Loop Syndrome/SIBO). * **Stage IV:** B12 + Pancreatic enzymes (Corrects in Chronic Pancreatitis). * **Note:** The Schilling test is now largely obsolete in clinical practice due to the availability of anti-intrinsic factor antibody assays and the scarcity of radioactive isotopes.
Explanation: **Explanation:** **Hemophilia B (Christmas Disease)** is an X-linked recessive bleeding disorder caused by a deficiency of **Clotting Factor IX** [1]. **1. Why Hemorrhage is the Correct Answer:** Despite significant advancements in replacement therapy, **hemorrhage** remains the leading cause of mortality in patients with Hemophilia B. Specifically, **Intracranial Hemorrhage (ICH)** is the most common cause of death related to bleeding. It can occur spontaneously or following minor trauma [1]. Other life-threatening sites include the gastrointestinal tract and the airway (due to retropharyngeal hematomas) [1]. **2. Why the Incorrect Options are Wrong:** * **B. HIV, HBV, HCV:** Historically, transfusion-transmitted infections were a major cause of death. However, with the advent of viral inactivation methods (heat treatment, solvent-detergent) and the use of **recombinant factor concentrates**, the risk of viral transmission has been virtually eliminated in modern practice [1]. * **C. Transfusion reactions:** While allergic reactions or inhibitor formation (neutralizing antibodies) can complicate treatment, they are rarely fatal. * **D. Deep vein thrombosis:** Hemophilia is a hypocoagulable state; DVT is extremely rare unless the patient is over-replaced with prothrombin complex concentrates (PCC) or has other significant risk factors [1]. **Clinical Pearls for NEET-PG:** * **Most common site of bleeding:** Hemarthrosis (specifically the knee joint) [1]. * **Most common cause of death:** Intracranial Hemorrhage. * **Diagnosis:** Prolonged aPTT, normal PT, and normal bleeding time. * **Treatment of choice:** Recombinant Factor IX [1]. (Note: Desmopressin/DDAVP is useful in Hemophilia A but **ineffective** in Hemophilia B [1]). * **Inhibitor formation:** Less common in Hemophilia B (approx. 3-5%) compared to Hemophilia A (approx. 25-30%).
Explanation: Explanation: Hepatitis-associated aplastic anemia (HAAA) is a distinct clinical syndrome where pancytopenia follows an episode of acute hepatitis. Why the correct answer is right: In the majority of cases (up to 90%), the causative agent is not one of the known hepatotropic viruses (A, B, C, D, or E). Instead, it is attributed to Non-A, Non-B, Non-C, Non-E hepatitis viruses [1]. The pathophysiology involves an immune-mediated destruction of hematopoietic stem cells. It is believed that an unknown virus triggers a T-cell-mediated (CD8+ cytotoxic T-lymphocytes) inflammatory response that cross-reacts with bone marrow antigens, leading to marrow aplasia. Why other options are incorrect: * Hepatitis A, B, and C: While there are rare case reports of aplastic anemia following infection with these specific viruses, they are statistically insignificant causes of HAAA. In standard clinical practice and for examination purposes, HAAA is specifically linked to seronegative (Non-A-E) hepatitis. High-Yield Clinical Pearls for NEET-PG: * Demographics: Most commonly affects young males. * Timeline: Aplastic anemia typically develops 2 to 3 months after the peak of the acute hepatitis episode. * Severity: The hepatitis is usually mild or resolving when the anemia begins, but the subsequent bone marrow failure is often severe or even fatal if untreated. * Treatment: The treatment of choice is Allogeneic Bone Marrow Transplantation (if a donor is available) or Immunosuppressive Therapy (IST) with Antithymocyte Globulin (ATG) and Cyclosporine. * Prognosis: Without treatment, the mortality rate is very high.
Explanation: ***Cold autoimmune hemolytic anemia (AIHA)*** - Presentation in **December** (cold weather) with **cyanosis** and **bluish lips** indicates **cold agglutinins** causing vascular occlusion and hemolysis at low temperatures. - **RBC agglutination** (clumping) on peripheral blood smear is the hallmark feature, along with **fatigue** from hemolysis and **arthralgia** from immune complex deposition. *Warm autoimmune hemolytic anemia (AIHA)* - Occurs at **body temperature** (37°C) and would not be triggered by cold weather or cause **acrocyanosis**. - Peripheral blood smear shows **spherocytes** rather than **RBC agglutination**, and **direct Coombs test** is positive for **IgG**. *Hemoglobinopathy* - Structural or quantitative **hemoglobin disorders** like sickle cell disease or thalassemia would show characteristic **RBC morphology** (sickle cells, target cells). - Symptoms are typically **chronic** from childhood and not specifically triggered by **cold weather** exposure. *G6PD Deficiency* - **X-linked disorder** causing hemolysis triggered by **oxidative stress** from medications, foods (fava beans), or infections. - Peripheral blood smear shows **bite cells** and **Heinz bodies**, not **RBC agglutination**, and symptoms are episodic rather than cold-induced.
Explanation: **Explanation:** **Upshaw-Schulman syndrome (USS)** is the rare, autosomal recessive form of **Inherited Thrombotic Thrombocytopenic Purpura (TTP)**. It is caused by a congenital deficiency of the **ADAMTS13** enzyme (a von Willebrand factor-cleaving protease). Without this enzyme, ultra-large von Willebrand factor (ULVWF) multimers accumulate, leading to spontaneous platelet aggregation, microangiopathic hemolytic anemia (MAHA), and widespread microvascular thrombosis. **Analysis of Options:** * **Option A (Correct):** USS is defined by a germline mutation in the *ADAMTS13* gene. Patients typically present in infancy or during physiological stress (like pregnancy) with severe thrombocytopenia and schistocytosis. * **Option B:** Acquired TTP is much more common and is caused by **autoantibodies (IgG)** against ADAMTS13, rather than a genetic deficiency. * **Option C:** While TTP *presents* with microangiopathic hemolytic anemia, this is a clinical feature, not a classification of the syndrome itself. * **Option D:** TTP is a peripheral destructive process; the bone marrow is typically hypercellular (compensatory erythropoiesis) rather than failing. **High-Yield Clinical Pearls for NEET-PG:** * **Classic Pentad of TTP:** Fever, Microangiopathic Hemolytic Anemia (MAHA), Thrombocytopenia, Neurological symptoms, and Renal dysfunction (**Mnemonic: FAT RN**). * **Diagnostic Marker:** ADAMTS13 activity levels **<10%**. * **Treatment:** In USS (Inherited), the mainstay is **Fresh Frozen Plasma (FFP)** to replace the missing enzyme. In Acquired TTP, the treatment of choice is **Plasmapheresis (PEX)** to remove antibodies. * **Schistocytes:** Presence of fragmented RBCs on peripheral smear is a hallmark finding.
Anemia Evaluation and Management
Practice Questions
Hemoglobinopathies
Practice Questions
Thalassemias
Practice Questions
Platelet Disorders
Practice Questions
Coagulation Disorders
Practice Questions
Thrombotic Disorders
Practice Questions
Leukemias
Practice Questions
Lymphomas
Practice Questions
Multiple Myeloma and Plasma Cell Disorders
Practice Questions
Myeloproliferative Neoplasms
Practice Questions
Transfusion Medicine
Practice Questions
Hematopoietic Stem Cell Transplantation
Practice Questions
Get full access to all questions, explanations, and performance tracking.
Start For Free